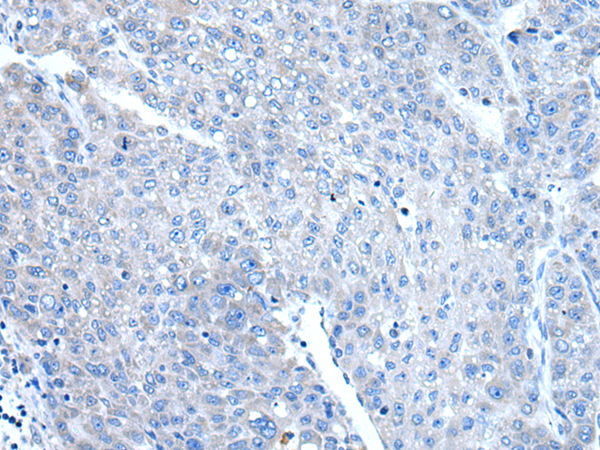

此商品无价格,无法添加至购物车内,系统已自动发起询价,
询价单号 点击跳转查看 X
询价单号 点击跳转查看 X



Order NO. D120546
兔抗DAP多克隆抗体
| 编 号 | 规格 | 库存 | 目录价(¥) | 您的价格(¥) | 数 量 |
| D120546-0025 | 25 ul | 现货 | 500 | 500 | |
| D120546-0100 | 100 ul | 现货 | 1600 | 1600 | |
| D120546-0200 | 200 ul | 现货 | 2500 | 2500 |
产品描述
概述
This gene encodes a basic, proline-rich, 15-kD protein. The protein acts as a positive mediator of programmed cell death that is induced by interferon-gamma. Alternatively spliced transcript variants encoding distinct isoforms have been found for this gene.
应用
酶联免疫吸附测定(ELISA),免疫组织化学(IHC)
属性
| 保存缓冲液 | -20°C, pH7.4 PBS, 0.05% NaN3, 40% Glycerol |
| 运输条件 | 2-8°C |
| 靶点 Uniprot 登记号 | P51397 |
| 靶点基因 ID | 1611 |
| 靶点全称 | death-associated protein |
| 靶点研究领域 | Cancer |
| 亚型 | Immunogen-specific rabbit IgG |
选择结算方或PI
申请授权记录
申请授权























 精确搜索
精确搜索 我的草稿
我的草稿
 我的购物车
我的购物车

 精确搜索
精确搜索